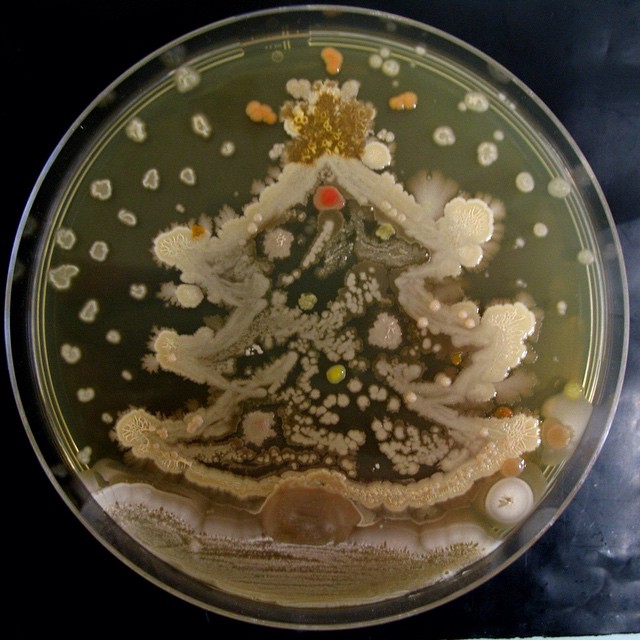

La Fing, AlireAilleurs et InternetActu.net vous souhaitent de très bonnes fêtes de fin d’année et vous donnent rendez-vous en 2015 !
Image : Un arbre de noël réalisé grâce à une microculture biologique par Rositsa Tashkova de l’université de Nantes via MicrobeWorld.
0 commentaires
Bonne et heureuse année avec des logiciels gratuits à télécharger pour protéger votre ordinateur des programmes malveillants sur internet